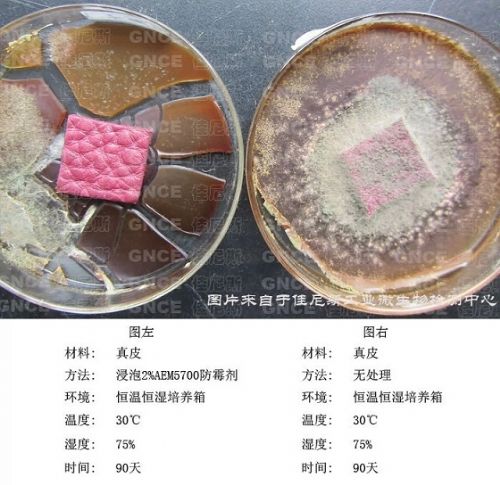

河北蓝凯节能科技有限公司皮料防霉抗菌剂AEM5700-PF-3
![]() |
-
AEM5700-PF-3皮革防霉剂根据皮革的成分特点和霉菌生长繁殖特点,通过多次的实验与验证,研发出的皮革防霉剂,在皮革防霉问题上取得很大的进展。皮革及皮革制品中含有大量的油脂、糖类、胶原蛋白、游离氨基酸,给霉菌以及细菌提供了丰富的营养,大大加快了霉菌、细菌的生长繁殖,让皮革产品遭受分解,失去光泽,韧性,耐用等价值。皮革防霉剂AEM5700-PF-3的广谱性、长久性在众多皮革防霉剂中独占鳌头,得到皮革制品生产厂家的青睐。
皮革防霉剂产品参数
有效成分 98% 
性状 液体
PH值 5.8-6.5 
颜色 红色
产品规格 25公斤/桶 
型号 AEM5700-PF-3
保质期 12个月 
稳定性 150度以下稳定
应用范围:真皮酒囊、真皮钥匙坠、真皮手环、真皮象棋、皮制沙发、皮制椅子、旅行袋、
手提包、背包、双肩背包、挎包、皮衣、皮裤、皮带等皮革服装
使用方法:在铬鞣过程中使用:建议在铬粉加20-30分钟后加入0.2—0.3%。
在加脂过程中使用:建议加入加脂剂重量的0.3-0.6%。
在涂饰过程中使用:建议加入涂饰剂的0.8-2%。
皮革防霉等级测试
温馨提示1:特别容易发霉确一直没有办法预防发霉的皮料,或者一些含油脂较重及一些新材料,建议寄往我司微生物检测中心进行防霉等级测试,通过数据给您*佳的使用方法。
温馨提示2:使用本产品时请带上口罩、橡胶手套,防止部分皮肤直接接触出现过敏。
温馨提示3:包装为25公斤/桶,储存于阴暗干燥处,切勿阳光直晒。
温馨提示4:使用时不慎溅在眼睛或皮肤上,立即用肥皂水进行清洗,出现过敏严重者立即就医。
- 广州佳伲斯防霉抗菌科技有限公司
主营业务:防霉剂:皮革防霉剂 木材防霉剂 纺织防霉剂 橡塑防霉剂 竹材防霉剂 编藤防霉剂 涂料防霉剂
联 系 人 :杨春
联系方式:020-86532540 18102203497 → 联系我时请告知是在建材采购网看到的
详情介绍更新时间:2015/7/27 14:45:06
相关产品

- 煤炭固沙抑尘剂厂家批发
价格:电询
煤炭固沙抑尘剂符合国家铁路标准该产品来自于生态科技有限公司,是治理扬尘的一款主打产品。粉尘抑制剂是一种环..

- 锅炉水垢清除剂
价格:电询
锅炉水垢清除剂 【适用对象】各种锅炉,电热锅炉 【主要成分】食品酸、渗透剂、促进剂、缓蚀剂、金属材料保..

- 铁路煤炭抑尘剂生产厂家
价格:电询
河北蓝凯煤炭的储存和运输过程中,会产生大量煤尘,不仅造成煤炭损失,还将对环境造成严重污染.通过实验确定了..

- 中央空调阻垢剂 中央空调杀菌剂厂家
价格:电询
产品说明 空调冷冻水处理剂是由高分子聚合物、有机膦酸盐、聚羧酸盐、无机盐、缓蚀剂等为主要成份复合而成。 ..

- 陶氏反渗透膜阻垢剂
价格:电询
1)2)陶氏反渗透膜阻垢剂是一种高效的液体阻垢、分散剂,本药剂为标准液,在很大的浓度范围内有效的控制无机..

- 循环冷却水缓蚀阻垢剂
价格:电询
循环冷却水缓蚀阻垢剂 循环水缓蚀阻垢剂是众多缓蚀阻垢剂中适用PH值范围最宽的一种,它是由有机酸盐、活..

- 锅炉防丢水染色剂
价格:电询
锅炉防丢水染色剂电话:13131639555 臭味剂可以有效监测锅炉管道泄漏:未知寒冷的冬季,室内取暖的..

- 换热器除垢剂 锅炉除垢剂
价格:电询
换热器除垢剂现货秒发 换热器清洗剂PH值多少本产品符合国家标准,是由高效的酸性除垢剂、渗透剂、螯合剂和污..

